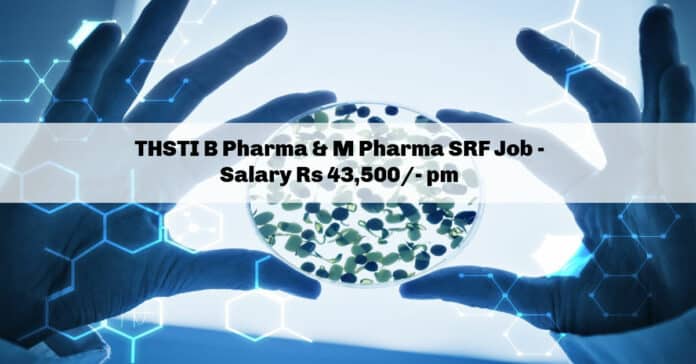

THSTI B Pharma & M Pharma SRF Job – Salary Rs 43,500/- pm
THSTI Hiring candidates with bachelor’s and master’s degree in pharma may apply for the job opening at THSTI for the post of Senior Research fellow. SRF job opening 2022. Senior Research Fellow job opening 2022, B pharma & M Pharma job opening 2022. Intrested and eligible candidates may check out all the details on the same below:
Project Title: “Sepsis-related mortality in neonates in India: A multi-disciplinary, multi-institutional research program for context-specific solutions”
Job Title: Senior Research Fellow,
No.of posts: 06
Consolidated salary per month Up to Rs 43,500
Duration 38 months
Age 18-30 years
Location University College of Medical Science, New Delhi Dr. Baba Saheb Ambedkar Hospital, New Delhi
Qualifications and Experience
B.Pharma with 2 years of research experience. OR MBBS/BDS/MVSc./M.Pharma degree holders
Job profile The Senior Research Fellow will be responsible for:
- Processing of samples received in the lab
- Preparation of reports
- Ensuring of lab supplies for study work
- Coordinate maintenance of the equipment log, calibration logs, ensuring smooth functioning of equipment at the site by lab attendant
- Maintain accurate records of lab study-specific methods and processes.
- Coordinate with the field worker for transport of the samples
Skills
- Ability to gain trust and confidence with stakeholders
- Operational skills including focus and commitment to quality management
and problem-solving - Influencing skills including negotiation and teamwork
- Effective communication skills, the provision of timely and accurate information to stakeholders
- Ability to develop and implement clinical research monitoring plans, SOPs,
database concepts, and formats - Understanding of GCP, regulations, and guidelines
- Excellent computer skills (MS word, excel, internet)
- Knowledge of adverse medical event investigation, analysis, reporting procedures and standards
GENERAL TERMS & CONDITIONS: –
a) These are short-term positions and extension will be granted subject to satisfactory
performance of the incumbents and tenure of the project for which they are selected.
Those appointed to these positions will not have any claim for regularization of their
employment.
b) All educational, professional, and technical qualifications should be from a recognized
Board/University.
c) The experience requirement specified above shall be the experience acquired after
obtaining the minimum educational qualifications specified for the post.
d) Closing date of the online application will be the CRUCIAL DATE for determining eligibility with regard to age, essential qualification, etc.
e) The age limit, qualification, experience, and other requirements may be relaxed at the
discretion of the competent authority, in case of candidates who are otherwise suitable.
In case candidates are not found suitable for the posts notified, they can be offered
lower post / lower emoluments on the recommendation of the Selection Committee.
f) Age and other relaxations for direct recruits and departmental candidates: 1. By five
years for candidates belonging to SC/ST communities. 2. By three years for candidates
belonging to OBC communities. 3. For Persons with Benchmark Disabilities (PWBD)
falling under the following categories: (i) UR – ten years, ii) OBC – 13 years (iii) SC/ST – 15
Age is relaxable for Central Government servants up to five years in accordance with
the instructions or orders issued by the Central Government, from time to time.
There is no upper age limit for the Institute employees who are treated as departmental
candidates. For Ex-servicemen up to the extent of service rendered in defense forces
(Army, Navy & Air force) plus 3 years provided they have put in a minimum of 6 months
attested service.
g) All results will be published on our website and all future communications will be only
through email.
h) In case a large number of applications are received, the screening will be done to limit the number of candidates to those possessing higher/relevant qualifications and experience.
i) With regard to any provisions not covered in this notification, the bye-laws of THSTI /
Govt. of India rules/guidelines shall prevail.
j) Canvassing in any form will be a disqualification
How To Apply:
1. Documents to be kept handy before filling up the online application: all the
documents except (i) should be in pdf format: –
i) A soft copy of your passport size photo and signature. (jpeg/jpg/png format)
ii) A comprehensive CV containing details of qualification, positions held, professional
experience / distinctions etc.
iii) Matriculation certificate (equivalent to 10th Standard) / Mark sheet)
iv) Intermediate certificate (equivalent to 12th Standard) / Mark sheet)
v) Graduation/Diploma degree certificate / Mark sheet
vi) Post-Graduation degree certificate & Mark sheet (if applicable)
vii) Ph.D./MD Degree (if applicable)
viii) Relevant experience certificates (if applicable)
ix) Caste / Disability certificate in the format prescribed by the Govt. of India, if
applicable
2. Procedure for filling up online application:
i) The eligible and interested candidates may apply online at the Institute’s website
www.thsti.res.in/career. Applications through any other mode will not be
accepted.
ii) The following will be the stepwise procedureA)
Step 1: Details of applicant
B) Step 2: Uploading of documents
C) Step 3: Payment of application fee
- The payment can be made by using Debit Card / Credit Card / Internet Banking / UPI.
- Once payment is made, no correction/modification is possible
- Candidates are requested to keep a copy of the provisional receipt for future reference.
- Fee once paid shall not be refunded under any circumstances.
- Details of fees to be paid are as shown below
| S.No | Applying on direct recruitment | Application fee amount |
| 1. | Unreserved, OBC & EWS candidates | Rs 236/- |
| 2. | SC/ST/Women/PwBD | Rs 118/- |
D) Step 4: Submission of application form
iii) On successful submission of the application, an auto-generated email containing the
reference number will be sent to the email address provided. Please keep a note of
the reference number for future correspondence.
iv) Candidates are required to keep a printout of the online application form by using
the print button on the dashboard for future reference.
v) Candidates must ensure that he/she fulfils all the eligibility criteria as stipulated in
the advertisement. If it is found that he/she does not fulfill the stipulated criteria
during the recruitment process, the candidature of the candidate will be canceled.
If the same is noticed after the appointment, the candidate will be terminated
following due process.
vi) Incomplete applications shall be summarily rejected and no correspondence in this
regard shall be entertained.
vii) In case of difficulty in filling up the online form, please send an e-mail to
personnel@thsti.res.in along with the screenshot of the error displayed (if any).
View Main Notification
Editors Note: THSTI B Pharma job, THSTI B Pharma vacancy, THSTI B Pharma Subscribe to Rasayanika for the latest chemistry and Pharma job openings, follow us on Facebook and Telegram and subscribe to our youtube channel for the latest updates on chemistry and Pharma jobs and much more.